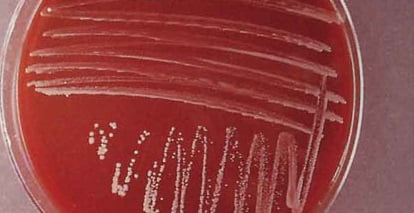
Бруцеллез у человека лечение

Бруцеллёз (мальтийская лихорадка) — зоонозное инфекционное заболевание, вызываемое различными видами бруцелл.
Болезнь склонна к хроническому течению и характеризуется неспецифической клинической картиной с множественным поражением различных органов и систем организма человека. Очень важно своевременно обнаружить симптомы бруцеллеза, опытный врач без труда распознает их при первом обследовании.
Возбудитель бруцеллеза не что иное, как мелкие микроорганизмы, хорошо адаптированные к любым условиям внешней среды, носящие название бруцеллы. Они не погибают при низких температурах, могут находиться в почве, на шерсти домашних животных, в коровьем молоке, а также в воде и замороженном мясе. И при этом сохранность бруцелл колеблется от 1,5 до 5 месяцев. При повышении температуры до 100°С бруцеллы погибают.
Синонимы болезни — мальтийская гипертермия, гипертермия Кипра, гипертермия Гибралтара, волнообразная гипертермия, септицемия Брюса, патология Банга.
Что такое бруцеллез?
Как можно заразиться бруцеллезом, и что это такое? Бруцеллез — зоонозная инфекция, характеризующаяся полиорганными патологиями и склонностью к хронизации. Значимым патогенетическим компонентом бруцеллеза является аллергическая реактивность. Возбудители бруцеллёза относятся к бактериям рода Brucella, среди которых признано существование восьми самостоятельных видов, шесть из которых способны вызывать заболевание у людей: B.melitensis, В.abortus, B.suis, B.canis, B.pinnipediae, B.cetaceae.
Из часто встречаемых видов бруцелл B.melitensis является наиболее вирулентной и вызывает наиболее тяжёлые и острые случаи заболевания. B.suis ассоциируется с продолжительным течением заболевания, сопровождающимся развитием гнойных деструктивных повреждений. B.abortus и B.canis, как правило, вызывают лёгкие либо средней тяжести спорадические заболевания с редким развитием осложнений. Случаи заболевания, вызванные B.pinnipediae и B.cetaceae, были описаны относительно недавно.
Передача инфекции осуществляется преимущественно фекально-оральным механизмом, чаще всего пищевым и водным путем, в некоторых случаях возможна реализация контактно-бытового (при внедрении возбудителя через микротравмы кожи и слизистых оболочек) и аэрогенного (при вдыхании инфицированной пыли) пути.
Значительную эпидемиологическую опасность представляют собой молоко, полученное от больных животных и молочные продукты (брынза, кумыс, сыры), мясо, изделия из животного сырья (шерсть, кожа). Животные загрязняют испражнениями почву, воду, корм, что также может способствовать заражению человека непищевым путем. Контактно-бытовой и воздушно-пылевой пути реализуются при уходе за животными и обработке животного сырья.

Симптомы бруцеллеза у человека
Инкубационный период бруцеллеза 7 дней — 8 недель, чаще 2 недели. Симптомы бруцеллеза у человека развиваются, обычно, постепенно и не имеют особенных характеристик.
Однако больные, как правило, предъявляют 4 основные жалобы:
- Перемежающаяся болезненность в суставах, по большей части в нижних конечностях, время от времени очень мучительная и сильная.
- Увеличение температуры тела в виде длительного субфебрилитета (до 38 °C) или волнообразного типа с резкими подъёмами и падениями.
- Усиленная потливость, испарина, временами ночная потливость.
- Резкая астения и упадок сил.
У некоторых больных отмечают длительный субфебрилитет. Лихорадка может длиться месяцами, типично, что даже при высокой температуре больные сохраняют сознание, селезенка и печень увеличены. Бруцеллез часто поражает нервную, половую системы и опорпо-двигательный аппарат.
Отмечаются также артриты (тазобедренного, крестцово-подвздошного и других крупных суставов), периартерииты, бурситы, тендо-вагиннты, спондилиты, невралгии, невриты (седалищный), реже — менингиты, энцефалиты и т. д. У мужчин бывают орхиты, эпидидимиты, а у женщин — дисменорреи, оофориты, сальпингиты и даже аборты.
Хроническая форма
Наступает хроническая форма в случае адаптации организма к возбудителю, при этом у человека признаки заболевания периодически обостряются и утихают. Данной форме свойственна симптоматика в виде лёгкой интоксикации и отсутствие повышения температуры тела (иногда до 37,5). Если же заболевание переходит в ремиссионную форму обострения, то у человека наблюдается симптоматика схожая с острым видом. Очень распространенным симптомом является увеличение лимфоузлов, печени и селезенки.
На данной стадии уже может происходить поражение многих внутренних органов, при этом наиболее часто под удар попадает опорно-двигательный аппарат, а в особенности суставы и крупные мышцы. Боли в суставах и их отекание вызваны неконтролируемым разрастанием костной ткани.
Результатом перехода бруцеллеза в хроническую форму могут быть невриты, радикулиты, менингиты, энцефалиты, метриты и другие заболевания, при этом беременные женщины с большим процентом вероятности теряют плод. У мужчин возбудители при хронической форме недомогания вызывают сбои гормонов, возникновение импотенции и в некоторых ситуациях бесплодия, что обуславливается негативным влиянием на яички.
Хронический вид заболевания может длиться на протяжении 2–3 лет, но если же происходит повторное инфицирование, то период становится значительно дольше.
Диагностика бруцеллеза
При обнаружении признаков заболевания для постановки диагноза, кроме анамнеза, необходимо провести некоторые лабораторные исследования.
Для этого человеку необходимо сдать анализы на бруцеллез, включающие 2 вида исследования:
- Серологическая диагностика — наиболее распространенный метод диагностики, при котором с помощью различных методик (реакция агглютинации, иммуноферментный анализ) проводится выявление нарастания титра антител к определенным видам бруцелл.
- Бактериологическое исследование с выделением культуры бактерий возбудителя и их идентификацией.
Для дополнительной диагностики, с целью определения выраженности и локализации структурных изменений органов, используется клинический анализ крови и мочи, рентгенологические и ультразвуковые методики инструментального обследования.
Лечение бруцеллеза у человека
При возникновении симптомов бруцеллеза, лечение заключается в уничтожении возбудителя, проникшего в организм человека. Обычно в качестве антибактериальной терапии медики назначают стрептомицин, левомицетин, а также другие антибиотики тетрациклиновой группы, которые успешно излечивают бруцеллез: лечение длится три-четыре недели и сопровождается дополнительной поддерживающей терапией.
При раннем обнаружении и своевременном лечении от заболевания можно успешно излечиться. Тяжелая форма бруцеллеза может привести к заражению центральной нервной системы, эндокардиту (воспалению внутренней оболочки сердца или сердечных клапанов), абсцессу печени. Кроме того, бруцеллез может вызывать затяжные симптомы, похожие на симптомы хронической усталости: периодическую лихорадку, слабость, утомление, боль в суставах.
Прогноз
При неправильном или неадекватном лечении, а также при терапии, которая была начата с опозданием, заболевание в 80% случаев становится хроническим. Бруцеллёз у человека, симптомы которого столь разнообразны, а лечение довольно длительно, редко является причиной смерти.
Однако надо помнить, что этот недуг очень часто приводит к инвалидности. И тяжесть остаточных явлений после перенесённого заболевания зависит от того, каким именно видом бруцелл произошло инфицирование. Самое тяжёлое осложнение — это поражение спинного мозга и параличи. Именно по этой причине большое внимание должно уделяться профилактике заболевания.
Профилактика
В случае бруцеллеза профилактика это — ликвидация бруцеллезных очагов среди животных и профилактика пищевых заражений, проведение специфической вакцинации лиц с 7-летнего возраста с отрицательными серологическими и аллергическими реакциями на бруцеллез при наличии показаний. Лица, вакцинированные живой противобруцеллезной вакциной, в целях профилактики допускаются к работе не ранее трех недель после прививки.